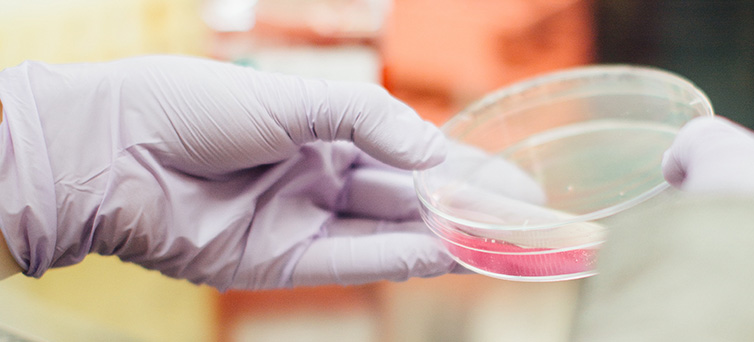

Homeopathy, also known as homeopathic medicine, is a medical system that was developed in Germany more than 200 years ago. It’s based on two unconventional theories: “Like cures like”—the notion that a disease can be cured by a substance that produces similar symptoms in healthy people “Law of minimum dose”—the notion that the lower the dose of the medication, the greater its effectiveness. Many homeopathic products are so diluted that no molecules of the original substance remain. Homeopathic products come from plants (such as red onion, arnica [mountain herb], poison ivy, belladonna [deadly nightshade], and stinging nettle), minerals (such as white arsenic), or animals (such as crushed whole bees). Homeopathic products are often made as sugar pellets to be placed under the tongue; they may also be in other forms, such as ointments, gels, drops, creams, and tablets. Treatments are “individualized” or tailored to each person—it’s common for different people with the same condition to receive different treatments.
A 2015 comprehensive assessment of evidence by the Australian government’s National Health and Medical Research Council concluded that there is no reliable evidence that homeopathy is effective for any health condition. Homeopathy is a controversial topic. A number of its key concepts don’t agree with fundamental scientific concepts. For example, it’s not possible to explain in scientific terms how a product containing little or no active ingredient can have any effect. This, in turn, creates major challenges to rigorous clinical investigation of such products. For example, researchers cannot confirm that an extremely dilute mixture contains what is listed on the label; nor have they been able to develop objective measures that show effects of extremely dilute products in the human body. Another research challenge is that homeopathic treatments are highly individualized, and there is no uniform prescribing standard for homeopathic practitioners. There are hundreds of different homeopathic remedies, which can be prescribed in a variety of different dilutions for thousands of symptoms.

There are effective remedies to help deal with possible problems during childbirth, such as a cervix which is slow to dilate, pain, excessive bleeding, retained placenta and other difficulties(3). Your homeopath will advise you and your partner on the use of remedies in labour. Ask your homeopath if he or she can attend the birth or if they will supply a labour kit with instructions for your partner to follow.
